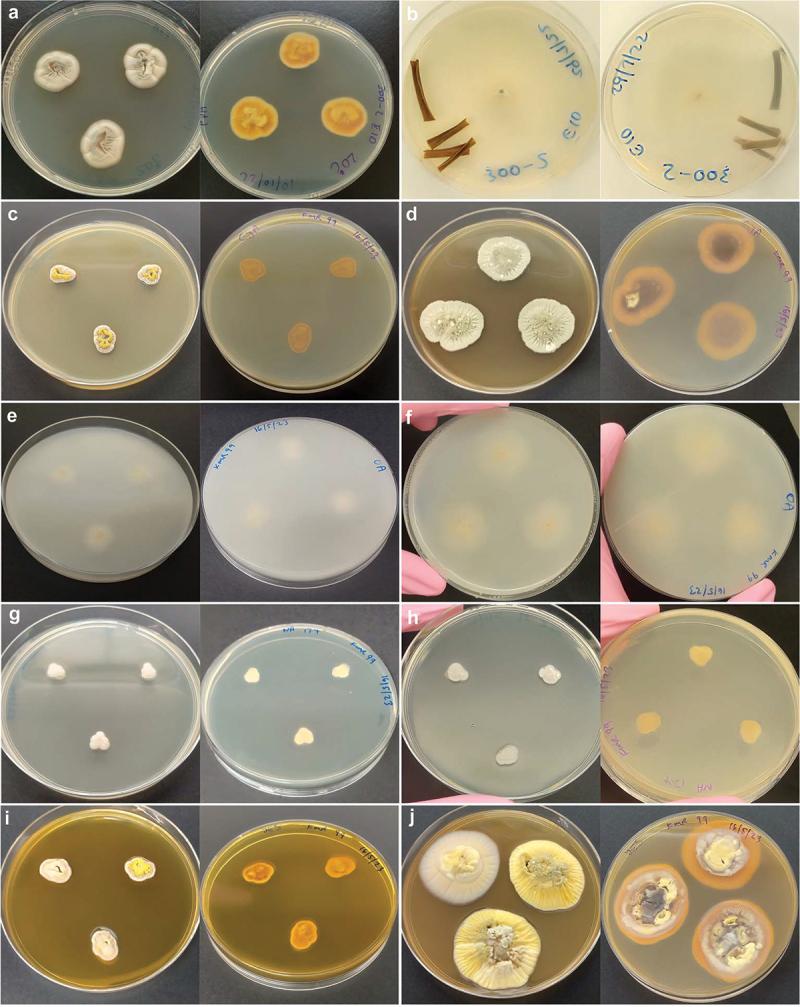
https://cdn.ncbi.nlm.nih.gov/pmc/blobs/4621/12422055/647d8a85690a/TMYC_A_2421319_F0003_OC.jpg

新物种,一种天然自发荧光的南极真菌。
sp. nov., a naturally autofluorescent Antarctic fungus.
作者信息
Furnell Alinta, Benaud Nicole, Vázquez-Campos Xabier, Liew Edward C Y, Mertin Allison, Vink Jordan A, Montgomery Kate, Wilkins Marc R, Summerell Brett A, Ferrari Belinda C
机构信息
School of Biotechnology and Biomolecular Sciences, The University of New South Wales, Sydney, Australia.
NSW Systems Biology Initiative, School of Biotechnology and Biomolecular Sciences, The University of New South Wales, Sydney, Australia.
出版信息
Mycology. 2025 Jan 2;16(3):1315-1338. doi: 10.1080/21501203.2024.2421319. eCollection 2025.
A new fungal species, sp. nov. is described as a member of section . The new species is sister to , and was isolated from soil collected from Robinson Ridge, East Antarctica, following enrichment cultivation under oligotrophic conditions supplemented with excess hydrogen gas. is named for its intense autofluorescence derived from a combination of compounds that may include NADPH, porphyrins, and secondary metabolites, such as polyketides. Comparative genomics with both Antarctic and mesophilic spp. shows that has a wide repertoire of glycoside hydrolases, but almost no polysaccharide lyases, has comparably large effector proteins, lacks the machinery to use nitrate as an N-source, but has the genes for the assimilation of phosphorus from phosphonates via oxidative pathway. The strain was found to have 30 biosynthetic gene clusters (BGCs), the majority of which were unrelated to known compound BGCs. Given the remarkable diversity of natural products already characterised from spp. and the presence of >30 BGCs with low similarity to known genes, there is biotechnological potential within this novel species that is yet to be explored.
一个新的真菌物种,[物种名称],被描述为[分类单元名称]组的一个成员。该新物种是[相关物种名称]的姐妹种,是在添加过量氢气的贫营养条件下进行富集培养后,从南极东部罗宾逊岭采集的土壤中分离出来的。[物种名称]因其强烈的自发荧光而得名,这种荧光源自可能包括NADPH、卟啉和聚酮类等次生代谢产物的化合物组合。与南极和嗜温[相关物种名称]物种的比较基因组学表明,[物种名称]具有广泛的糖苷水解酶,但几乎没有多糖裂解酶,具有相对较大的效应蛋白,缺乏将硝酸盐用作氮源的机制,但具有通过氧化途径从膦酸盐同化磷的基因。该菌株被发现有30个生物合成基因簇(BGCs),其中大多数与已知化合物的BGCs无关。鉴于已经从[相关物种名称]物种中鉴定出的天然产物具有显著的多样性,以及存在超过30个与已知基因相似度低的BGCs,这个新物种具有尚未被探索的生物技术潜力。